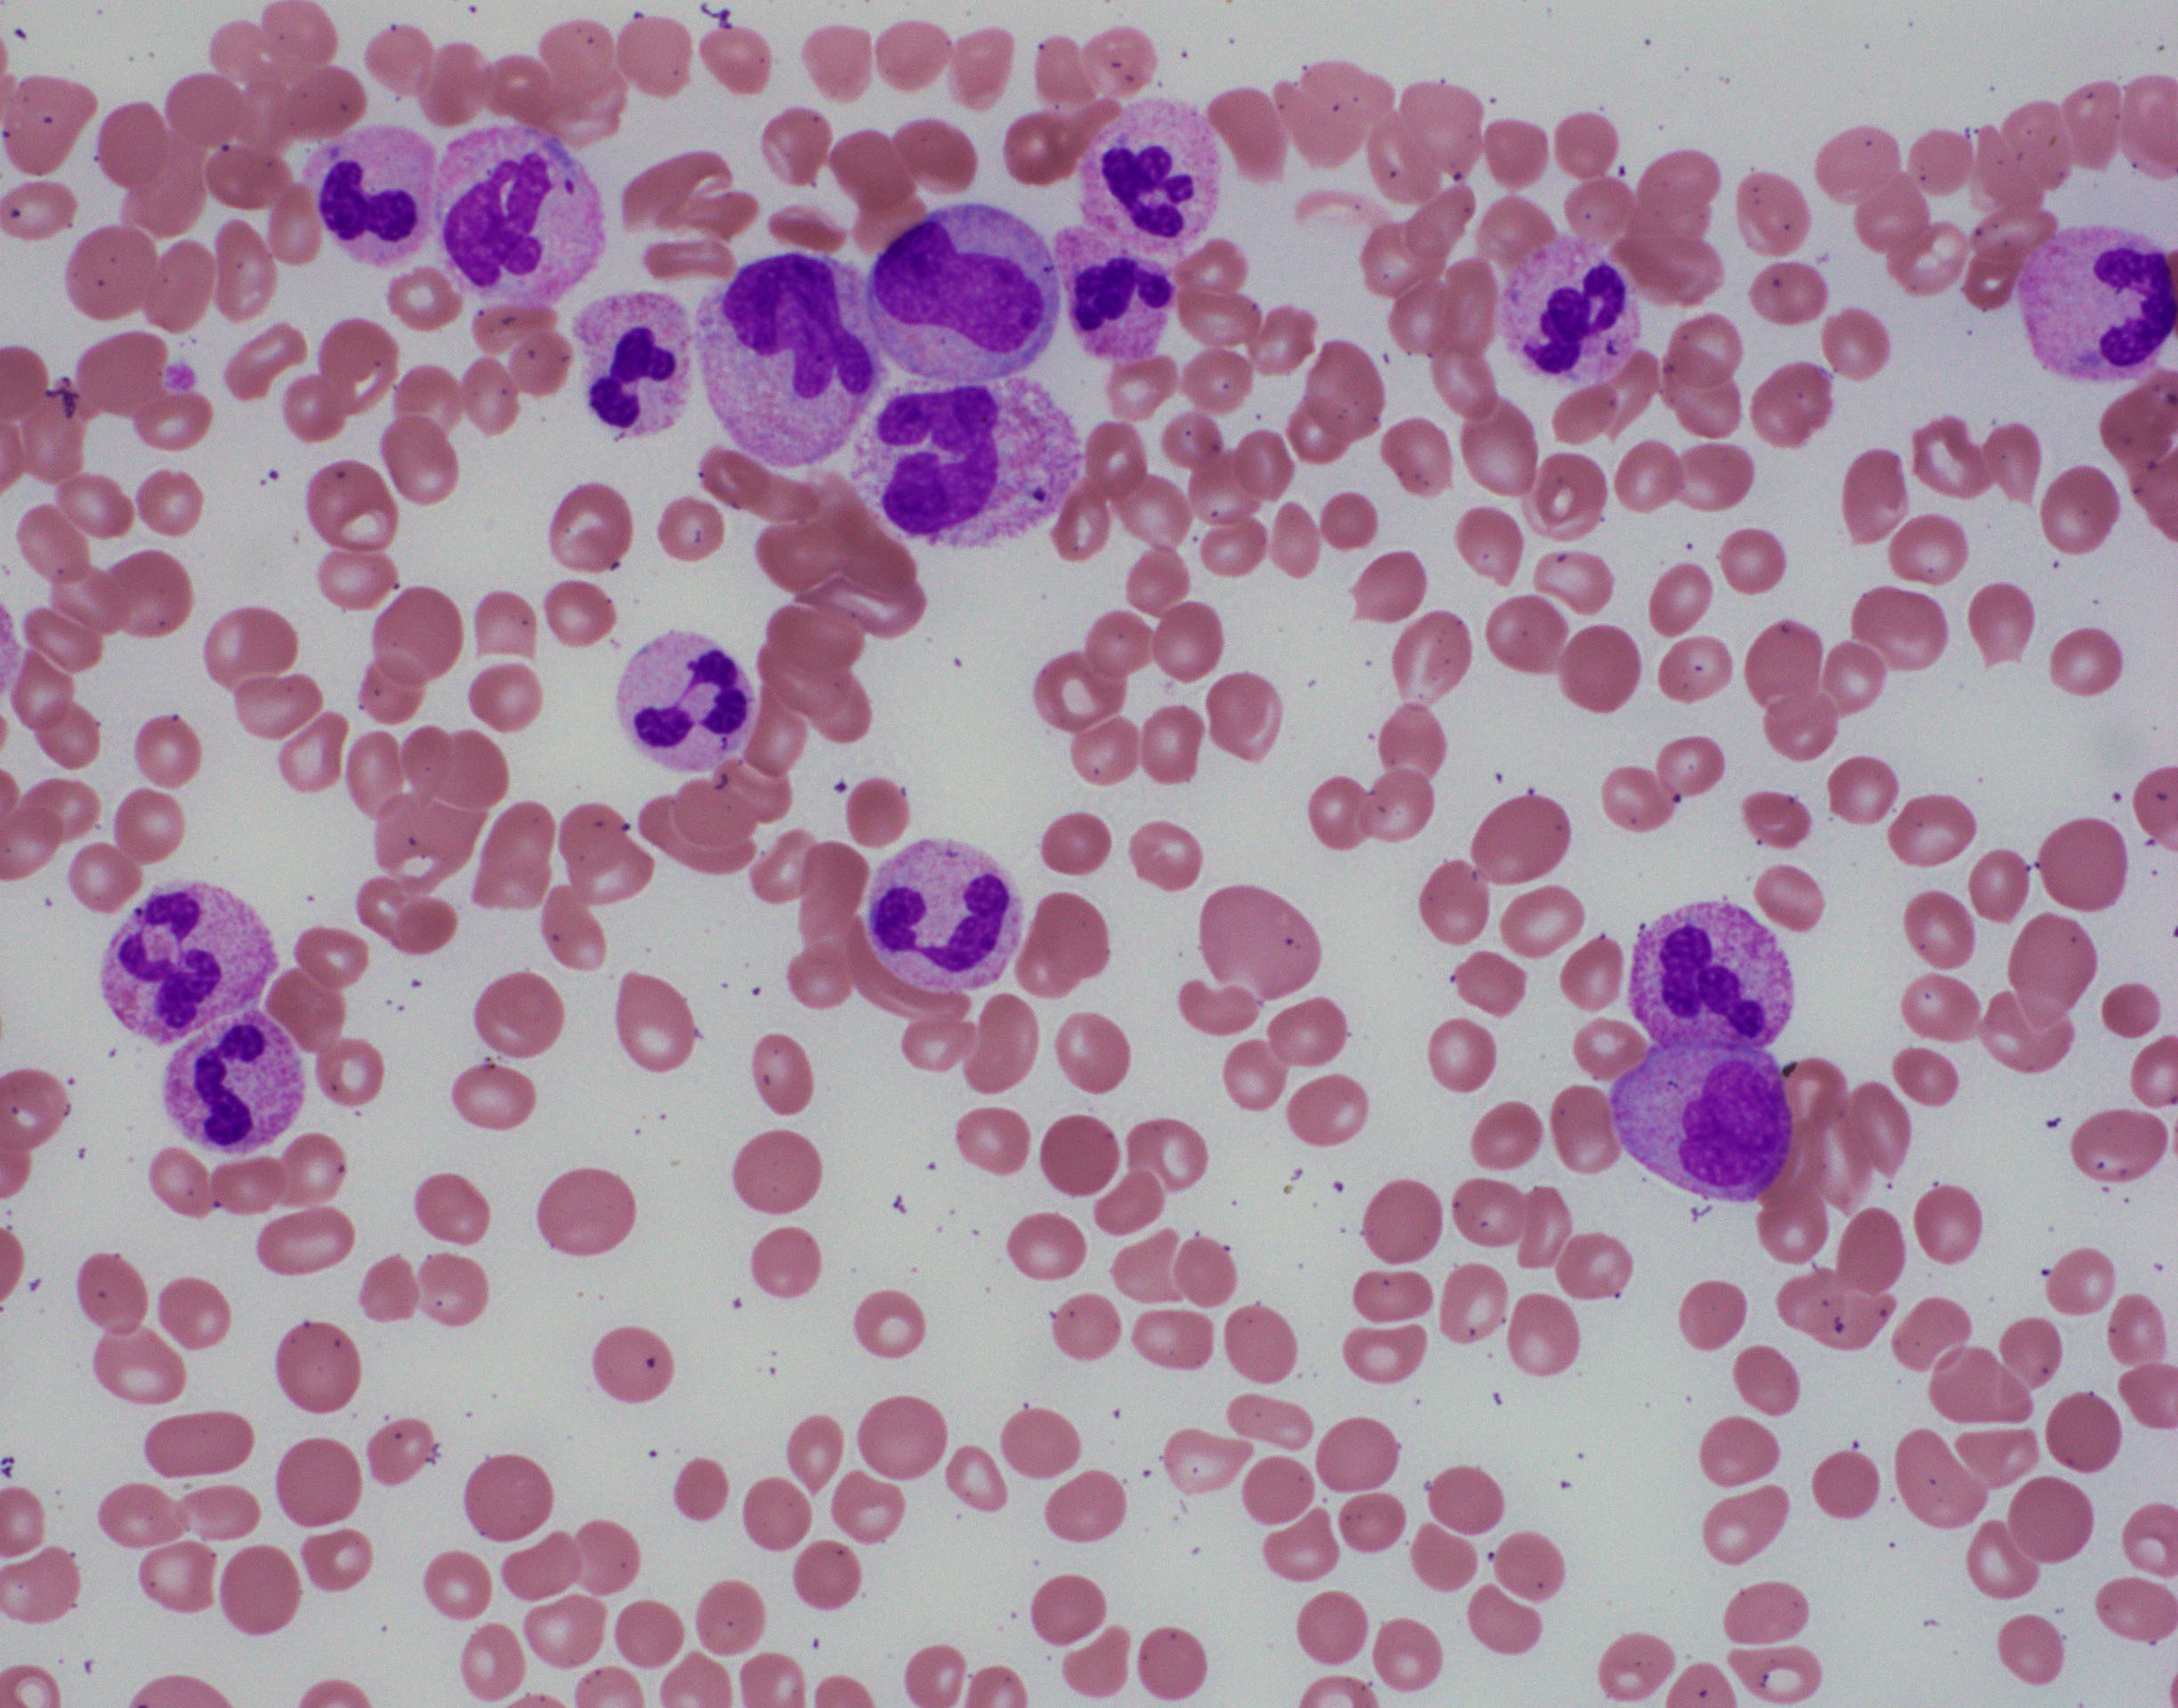

Myelodysplastic/myeloproliferative neoplasm with neutrophilia
Haematolymphoid Tumours (5th ed.)
| This page is under construction |
editHAEM5 Conversion NotesThis page was converted to the new template on 2023-11-03. The original page can be found at HAEM4:Atypical Chronic Myeloid Leukemia (aCML), BCR-ABL1 Negative.
Primary Author(s)*
Linsheng Zhang, MD, PhD
Cancer Category/Type
Myeloid neoplasm
Cancer Sub-Classification / Subtype
Myelodysplastic/Myeloproliferative Neoplasm
Definition / Description of Disease
Atypical chronic myeloid leukemia, BCR-ABL1-negative (aCML) presents with myelodysplastic as well as myeloproliferative features at the time of disease onset[1][2]. The characteristic finding is blood leukocytosis with increase of dysplastic neutrophils and immature granulocytes. Bone marrow shows multilineage dysplasia.
- Before the diagnosis of aCML can be rendered, myeloid neoplasms with well defined genetic abnormalities such as BCR-ABL1 fusion; rearrangement of PDGFRA, PDGFRB, FGFR1, or PCM1-JAK2 must be ruled out.
- Myeloid neoplasm with features of aCML developed after chemo or radiation therapy is classified as therapy-related myeloid neoplasm.
Synonyms / Terminology
Atypical chronic myeloid leukemia, Philadelphia chromosome-negative (Ph-)
Atypical chronic myeloid leukemia, BCR-ABL1-negative
Epidemiology / Prevalence
The incidence of aCML is low; it is estimated that there are 1-2 aCML cases for every 100 cases of BCR-ABL1-positive chronic myeloid leukemia[3][4].
The median patient age at diagnosis is in the seventh or eighth decade of life[4][5][6]. Rare cases of aCML has also been reported in teenagers. The reported male-to female ratio is approximately 1:1[1].
Clinical Features
Put your text here and fill in the table (Instruction: Can include references in the table)
| Signs and Symptoms | EXAMPLE Asymptomatic (incidental finding on complete blood counts)
EXAMPLE B-symptoms (weight loss, fever, night sweats) EXAMPLE Fatigue EXAMPLE Lymphadenopathy (uncommon) |
| Laboratory Findings | EXAMPLE Cytopenias
EXAMPLE Lymphocytosis (low level) |
editv4:Clinical FeaturesThe content below was from the old template. Please incorporate above.The primary symptoms are related to splenomegaly and blood cell changes like anemia and/or thrombocytopenia[5][7][6].
Sites of Involvement
- Blood and bone marrow are always involved.
- Involvement of spleen and liver is common.
Morphologic Features
BLOOD:
- The white blood cell count (WBC) ≥13 x 109/L, cases >300 x 109/L have been reported.
- Immature granulocytes, including promyelocytes, myelocytes, and metamyelocytes ≥10% of the leukocytes.
- Monocytes <10%.
- Mild basophilia.
- Dysplastic features observed in granulocytes:
- Acquired Pelger-Huët anomaly
- Other nuclear abnormalities (hypersegmentation with abnormally clumped nuclear chromatin or bizarrely segmented nuclei)
- Multiple nuclear projections
- Abnormal cytoplasmic granularity (usually hypogranularity).
- The syndrome of abnormal chromatin clumping is considered to be a morphologic variant of aCML[8].
- Neutrophil nuclei show large well-separated blocks of heterochromatin and euchromatin
- Anemia and thrombocytopenia are common.
BONE MARROW:
- Hypercellular with markedly increased myeloid-to-erythroid ratio (usually >10:1)
- Features of trilineage dysplasia
- Dyserythropoiesis is present in about 40% of cases.
- Dysgranulopoiesis with the changes in the neutrophil lineage similar to those in the blood.
- Megakaryocytes quantitatively variable, usually normal or increased, frequently with dysmegakaryopoiesis, including micromegakaryocytes and small megakaryocytes with hypolobated nuclei.
- Mild fibrosis seen in some cases; may be more conspicuous with disease progression.
By definition, blasts <20% of blood leukocytes (usually <5%) and <20% of bone marrow nucleated cells.


Immunophenotype
Put your text here and fill in the table (Instruction: Can include references in the table)
| Finding | Marker |
|---|---|
| Positive (universal) | EXAMPLE CD1 |
| Positive (subset) | EXAMPLE CD2 |
| Negative (universal) | EXAMPLE CD3 |
| Negative (subset) | EXAMPLE CD4 |
editv4:ImmunophenotypeThe content below was from the old template. Please incorporate above.No specific immunophenotypic characteristics (flow cytometric analysis of blood and bone marrow usually report as normal, except mildly increased myeloblasts in some cases).
Chromosomal Rearrangements (Gene Fusions)
Put your text here and fill in the table
| Chromosomal Rearrangement | Genes in Fusion (5’ or 3’ Segments) | Pathogenic Derivative | Prevalence | Diagnostic Significance (Yes, No or Unknown) | Prognostic Significance (Yes, No or Unknown) | Therapeutic Significance (Yes, No or Unknown) | Notes |
|---|---|---|---|---|---|---|---|
| EXAMPLE t(9;22)(q34;q11.2) | EXAMPLE 3'ABL1 / 5'BCR | EXAMPLE der(22) | EXAMPLE 20% (COSMIC)
EXAMPLE 30% (add reference) |
Yes | No | Yes | EXAMPLE
The t(9;22) is diagnostic of CML in the appropriate morphology and clinical context (add reference). This fusion is responsive to targeted therapy such as Imatinib (Gleevec) (add reference). |
editv4:Chromosomal Rearrangements (Gene Fusions)The content below was from the old template. Please incorporate above.None.
editv4:Clinical Significance (Diagnosis, Prognosis and Therapeutic Implications).Please incorporate this section into the relevant tables found in:
- Chromosomal Rearrangements (Gene Fusions)
- Individual Region Genomic Gain/Loss/LOH
- Characteristic Chromosomal Patterns
- Gene Mutations (SNV/INDEL)
Genetic abnormalities and mutations in related genes provide evidence of a clonal process to support a neoplastic process. However, they are not specific for aCML.
The prognostic value of molecular/genetic abnormalities are not well studied yet.
Approximately 20-40% of aCML evolves to acute myeloid leukemia[4]; most of the remaining patients die of marrow failure[7][9].
Predictors of worse prognosis:
- Age > 65 years
- Female sex
- White blood cell count > 50 x 109/L, thrombocytopenia and hemoglobin level < 10 g/dL[9].
- Increased blasts in blood and/or bone marrow.
Individual Region Genomic Gain/Loss/LOH
Put your text here and fill in the table (Instructions: Includes aberrations not involving gene fusions. Can include references in the table. Can refer to CGC workgroup tables as linked on the homepage if applicable.)
| Chr # | Gain / Loss / Amp / LOH | Minimal Region Genomic Coordinates [Genome Build] | Minimal Region Cytoband | Diagnostic Significance (Yes, No or Unknown) | Prognostic Significance (Yes, No or Unknown) | Therapeutic Significance (Yes, No or Unknown) | Notes |
|---|---|---|---|---|---|---|---|
| EXAMPLE
7 |
EXAMPLE Loss | EXAMPLE
chr7:1- 159,335,973 [hg38] |
EXAMPLE
chr7 |
Yes | Yes | No | EXAMPLE
Presence of monosomy 7 (or 7q deletion) is sufficient for a diagnosis of AML with MDS-related changes when there is ≥20% blasts and no prior therapy (add reference). Monosomy 7/7q deletion is associated with a poor prognosis in AML (add reference). |
| EXAMPLE
8 |
EXAMPLE Gain | EXAMPLE
chr8:1-145,138,636 [hg38] |
EXAMPLE
chr8 |
No | No | No | EXAMPLE
Common recurrent secondary finding for t(8;21) (add reference). |
editv4:Genomic Gain/Loss/LOHThe content below was from the old template. Please incorporate above.Karyotypic abnormalities are reported in as many as 80% of cases.
Characteristic Chromosomal Patterns
Put your text here (EXAMPLE PATTERNS: hyperdiploid; gain of odd number chromosomes including typically chromosome 1, 3, 5, 7, 11, and 17; co-deletion of 1p and 19q; complex karyotypes without characteristic genetic findings; chromothripsis)
| Chromosomal Pattern | Diagnostic Significance (Yes, No or Unknown) | Prognostic Significance (Yes, No or Unknown) | Therapeutic Significance (Yes, No or Unknown) | Notes |
|---|---|---|---|---|
| EXAMPLE
Co-deletion of 1p and 18q |
Yes | No | No | EXAMPLE:
See chromosomal rearrangements table as this pattern is due to an unbalanced derivative translocation associated with oligodendroglioma (add reference). |
editv4:Characteristic Chromosomal Aberrations / PatternsThe content below was from the old template. Please incorporate above.None.
Gene Mutations (SNV/INDEL)
Put your text here and fill in the table (Instructions: This table is not meant to be an exhaustive list; please include only genes/alterations that are recurrent and common as well either disease defining and/or clinically significant. Can include references in the table. For clinical significance, denote associations with FDA-approved therapy (not an extensive list of applicable drugs) and NCCN or other national guidelines if applicable; Can also refer to CGC workgroup tables as linked on the homepage if applicable as well as any high impact papers or reviews of gene mutations in this entity.)
| Gene; Genetic Alteration | Presumed Mechanism (Tumor Suppressor Gene [TSG] / Oncogene / Other) | Prevalence (COSMIC / TCGA / Other) | Concomitant Mutations | Mutually Exclusive Mutations | Diagnostic Significance (Yes, No or Unknown) | Prognostic Significance (Yes, No or Unknown) | Therapeutic Significance (Yes, No or Unknown) | Notes |
|---|---|---|---|---|---|---|---|---|
| EXAMPLE: TP53; Variable LOF mutations
EXAMPLE: EGFR; Exon 20 mutations EXAMPLE: BRAF; Activating mutations |
EXAMPLE: TSG | EXAMPLE: 20% (COSMIC)
EXAMPLE: 30% (add Reference) |
EXAMPLE: IDH1 R123H | EXAMPLE: EGFR amplification | EXAMPLE: Excludes hairy cell leukemia (HCL) (add reference).
|
Note: A more extensive list of mutations can be found in cBioportal (https://www.cbioportal.org/), COSMIC (https://cancer.sanger.ac.uk/cosmic), ICGC (https://dcc.icgc.org/) and/or other databases. When applicable, gene-specific pages within the CCGA site directly link to pertinent external content.
editv4:Gene Mutations (SNV/INDEL)The content below was from the old template. Please incorporate above.
Gene Mutation Oncogene/Tumor Suppressor/Other Presumed Mechanism (LOF/GOF/Other; Driver/Passenger) Prevalence SETBP1 D868N, S869N, G870S, I871T and D880N[10] Other: conferring self-renewal capability to myeloid progenitors[11] GOF 25-38%[12][13] Other Mutations
Gene/Mutation Prevalence[4] RAS (KRAS/NRAS) 35% ETNK1: H243Y and N244S 8.8%[14] JAK2: V617F 7% CSF3R <10% CALR <10% APC2 6%[13] Mutations in TET2, ASXL1, EZH2 and SRSF2 (overlapping with CMML) are not uncommon in aCML[15].
Epigenomic Alterations
Not well studied yet.
Genes and Main Pathways Involved
Put your text here and fill in the table (Instructions: Can include references in the table.)
| Gene; Genetic Alteration | Pathway | Pathophysiologic Outcome |
|---|---|---|
| EXAMPLE: BRAF and MAP2K1; Activating mutations | EXAMPLE: MAPK signaling | EXAMPLE: Increased cell growth and proliferation |
| EXAMPLE: CDKN2A; Inactivating mutations | EXAMPLE: Cell cycle regulation | EXAMPLE: Unregulated cell division |
| EXAMPLE: KMT2C and ARID1A; Inactivating mutations | EXAMPLE: Histone modification, chromatin remodeling | EXAMPLE: Abnormal gene expression program |
editv4:Genes and Main Pathways InvolvedThe content below was from the old template. Please incorporate above.Frequently involved:
- Cell proliferation and survival (SETBP1)
Less commonly involved:
- JAK/STAT pathway (JAK2)
- PI3K/AKT and MAPK/ERK (CSF3R)
Genetic Diagnostic Testing Methods
Blood cell counts and blood smear review (differential cell counts and dysplastic features).
Bone marrow aspirate smear review and biopsy histopathology (abnormal maturation pattern, blast percentage, etc.).
Molecular/genetic studies are of critical importance to establish clonal evidence and rule out other entities with well defined genetic abnormalities.
- Chromosome analysis
- Fluorescence in situ hybridization (FISH) to rule out PDGFRA, PDGFRB or FGFR1 rearrangement, BCR-ABL1 and PCM1-JAK2 fusion.
- Next generation sequencing-based mutation profiling to detect mutations supporting a clonal process.
Familial Forms
None
Additional Information
None
Links
Put your text placeholder here (or anywhere appropriate on the page) and use the "Link" icon at the top of the page (Instructions: Once you have a text placeholder entered to which you want to add a link, highlight that text, select the "Link" icon at the top of the page, and search the name of the internal page to which you want to link this text, or enter an external internet address including the "http://www." portion.)
References
(use the "Cite" icon at the top of the page) (Instructions: Add each reference into the text above by clicking on where you want to insert the reference, selecting the “Cite” icon at the top of the page, and using the “Automatic” tab option to search such as by PMID to select the reference to insert. The reference list in this section will be automatically generated and sorted. If a PMID is not available, such as for a book, please use the “Cite” icon, select “Manual” and then “Basic Form”, and include the entire reference.)
- ↑ 1.0 1.1 Orazi A, et al., (2017). Atypical chronic myeloid leukaemia, BCR-ABL1-negative, in World Health Organization Classification of Tumours of Haematopoietic and Lymphoid Tissues, Revised 4th edition. Swerdlow SH, Campo E, Harris NL, Jaffe ES, Pileri SA, Stein H, Thiele J, Arber DA, Hasserjian RP, Le Beau MM, Orazi A, and Siebert R, Editors. IARC Press: Lyon, France, p87-89.
- ↑ Czader, M and Orazi, A. Chapter 45. Myelodysplastic/Myeloproliferative Neoplasms and Related Diseases. In Orazi A, Foucar K, Knowles DM. eds. Knowles Neoplastic Hematopathology. Riverwoods, IL: Wolters Kluwer Health; 2013:1148-1150.
- ↑ A, Orazi; et al. (2008). "The Myelodysplastic/Myeloproliferative Neoplasms: Myeloproliferative Diseases With Dysplastic Features". PMID 18480833.
- ↑ 4.0 4.1 4.2 4.3 Sa, Wang; et al. (2014). "Atypical Chronic Myeloid Leukemia Is Clinically Distinct From Unclassifiable Myelodysplastic/Myeloproliferative Neoplasms". doi:10.1182/blood-2014-02-553800. PMC 4067498. PMID 24627528.CS1 maint: PMC format (link)
- ↑ 5.0 5.1 5.2 Jm, Hernández; et al. (2000). "Clinical, Hematological and Cytogenetic Characteristics of Atypical Chronic Myeloid Leukemia". PMID 10847463.
- ↑ 6.0 6.1 6.2 P, Martiat; et al. (1991). "Philadelphia-negative (Ph-) Chronic Myeloid Leukemia (CML): Comparison With Ph+ CML and Chronic Myelomonocytic Leukemia. The Groupe Français De Cytogénétique Hématologique". PMID 2070054.
- ↑ 7.0 7.1 R, Kurzrock; et al. (2001). "BCR Rearrangement-Negative Chronic Myelogenous Leukemia Revisited". PMID 11387365.
- ↑ Brizard, A.; et al. (1989). "THREE CASES OF MYELODYSPLASTIC-MYELOPROLIFERATIVE DISORDER WITH ABNORMAL CHROMATIN CLUMPING IN GRANULOCYTES". British Journal of Haematology. 72 (2): 294–295. doi:10.1111/j.1365-2141.1989.tb07703.x. ISSN 0007-1048.
- ↑ 9.0 9.1 M, Breccia; et al. (2006). "Identification of Risk Factors in Atypical Chronic Myeloid Leukemia". PMID 17043019.
- ↑ R, Acuna-Hidalgo; et al. (2017). "Overlapping SETBP1 Gain-Of-Function Mutations in Schinzel-Giedion Syndrome and Hematologic Malignancies". doi:10.1371/journal.pgen.1006683. PMC 5386295. PMID 28346496.CS1 maint: PMC format (link)
- ↑ Oakley, Kevin; et al. (2012). "Setbp1 promotes the self-renewal of murine myeloid progenitors via activation of Hoxa9 and Hoxa10". Blood. 119 (25): 6099–6108. doi:10.1182/blood-2011-10-388710. ISSN 0006-4971. PMC 3383018. PMID 22566606.CS1 maint: PMC format (link)
- ↑ Mughal, T. I.; et al. (2015). "An International MDS/MPN Working Group's perspective and recommendations on molecular pathogenesis, diagnosis and clinical characterization of myelodysplastic/myeloproliferative neoplasms". Haematologica. 100 (9): 1117–1130. doi:10.3324/haematol.2014.114660. ISSN 0390-6078. PMC 4800699. PMID 26341525.CS1 maint: PMC format (link)
- ↑ 13.0 13.1 Palomo, Laura; et al. (2020). "Molecular landscape and clonal architecture of adult myelodysplastic/myeloproliferative neoplasms". Blood. doi:10.1182/blood.2019004229. ISSN 0006-4971.
- ↑ Gambacorti-Passerini, Carlo B.; et al. (2015). "Recurrent ETNK1 mutations in atypical chronic myeloid leukemia". Blood. 125 (3): 499–503. doi:10.1182/blood-2014-06-579466. ISSN 0006-4971.
- ↑ Faisal, Muhammad; et al. (2019). "Comprehensive mutation profiling and mRNA expression analysis in atypical chronic myeloid leukemia in comparison with chronic myelomonocytic leukemia". Cancer Medicine. 8 (2): 742–750. doi:10.1002/cam4.1946. PMC 6382710. PMID 30635983.CS1 maint: PMC format (link)
Notes
*Primary authors will typically be those that initially create and complete the content of a page. If a subsequent user modifies the content and feels the effort put forth is of high enough significance to warrant listing in the authorship section, please contact the CCGA coordinators (contact information provided on the homepage). Additional global feedback or concerns are also welcome. *Citation of this Page: “Myelodysplastic/myeloproliferative neoplasm with neutrophilia”. Compendium of Cancer Genome Aberrations (CCGA), Cancer Genomics Consortium (CGC), updated 11/3/2023, https://ccga.io/index.php/HAEM5:Myelodysplastic/myeloproliferative_neoplasm_with_neutrophilia.